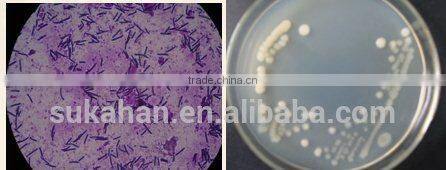

Home > Products > Biological Fertilizer > Biological Composting Agent for Making Fertilizer
Biological Composting Agent for Making Fertilizer
- Qingdao
- T/T
You May Like
Product Details
| Place of Origin | Shandong, China | Brand Name | SUKAAgri | |
| Model Number | C3009G | Type | Other, animal waste compost |
Product Description
SUKAAgri-C3009/G Biological Composting Agent for Making Fertilizer |
Quick Details: |
Brief Introduction: SUKAAgri-C3009/G is a biological bacteria for compost manure into fertilizer which is microbial-based product containing a concentrated blend of non-pathogenic beneficial organisms, multi-enzyme producing microorganisms that is directly added during the composting process. The microorganisms in the product utilize active digestive enzymes to degrade the organic matter and proteinaceous particles present in the composting material.The ‘heart solution’ is used to supplement the inherent culture during composting and enhance the decomposition of organic matter for the production of humus compost from proteins and agricultural solid wastes. |
Brand Name: SUKAAgri Model:C3009/G Origin:China Usage: Composting agent for protein-based materials |
Specification: |
1.Appearance: Black free flowing powder 2.Odor: Slight fermentation odor 3.PH Range: 6.5 - 8.0 4.Temperature: 15℃-70℃, Optimum: 25℃-65℃ 5.Bacteria Count: 2.0*10 to 9th |
Packing:20kg/carton |
Dosage 250g/ton of waste |
Advantage: l reduces the organic waste material destined for landfills l provides a useful way of reclaiming nutrients from organic refuse l one of nature's best mulches and soil amendments l supplement for commercial fertilizers l compost improves soil structure, texture, and aeration and increases the soil's water-holding capacity l compost loosens clay soils and helps sandy soils retain water l compost addition improves soil fertility and stimulates healthy root development in plants l the organic matter in compost provides food for microorganisms, which keeps the soil in a healthy, balanced condition l nitrogen, potassium, and phosphorus will be produced naturally by the feeding of microorganisms, so few soil amendments will need to be added l saves valuable landfill space and possible contamination of land and water due to landfill 'leachate' l can be used as fertilizer on farmland or in the garden
|
Component: SUKAAgri-C3009/G contains aerobic micro-organisms with specific biodegradative abilities which are able to grow and degrade organic substances during the composting process |
Contact Us
- Shandong Sukahan Bio-technology Co., Ltd.
- Contact nameLinda Han Chat Now
- Phone86-536-2225033
- AddressNo.2237, East Wolong Street, High &New Technology Industrial District, Weifang, Shandong, P.R. China, Weifang, Shandong
Product Categories
New Products
-
Product for Rich Fish Pond Water
-
Biological Product for Rich and Clean Pond Water
-
Biological Product for Rich Fish and Shrimp Pond Water
-
Biological Fertilizer for Phosphate Dissolving
-
Biological Fertilizer for Potassium Dissolving
-
Biological Fertilizer for Potassium and Phosphate Dissolving
-
Biological Fertilizer for Nitrogen Fixation
-
Using Plant Remains to Produce Organic Fertilizer
-
Composting Agent for Plant Remains Treatment
-
Composting Agent for Agricultural Materials Treatment
-
Composting Agent to Use Agricultural Materials Make Organic Fertilizer
-
Composting Agent to Use Plant Remains Make Organic Fertilizer
-
Composting Convert Organic Wastes to Fertilizer
-
Composting Agent for Animal Manure Treatment
-
Composting Agent Using Animal Manure to Make Organic Fertilizer
-
Composting Agent for Horse Ranch to Use Horse Manure Make Organic Fertilizer
-
Composting Agent for Piggery to Use Manure to Make Organic Fertilizer
-
Composting Agent for Sheep Farm to Use Manure Make Organic Fertilizer
-
Composting Agent for Cattle Farm to Use Manure Make Organic Fertilizer
-
Composting Agent for Chicken Farm to Make Organic Fertilizer
-
Composting Product Using Cow Chicken Manure to Make Organic Fertilizer
-
Composting Agent for Protein-based Materials
-
Cellulose/Agricultural Materials Composting Agent
-
SUKAST Bacteria for Septic Tank
Popular Searches
- water treatment
- water purifier
- water filter
- water purification
- manganese water filter
- water iron remove
- water tank
- water treatment system
- drinking system
- wastewater treatment equipment
- industrial equipment
- waste water treatment
- water filter system
- sewage treatment equipment
- water treatment equipment
- electric system
- wastewater treatment
- water plant
- dewatering machine
- oil treatment
- multistage centrifugal blower
- water softener
- chemical dosing system
- hospital waste
- waste water treatment equipment
- water storage tank
- uv sterilizer
- water filtration
- ro system
- drinking water filtration
Recommended Products
- Seawater Electrochlorine System
- BSHH-200 12% Sodium Hypochlorite Generator|Salt Water Electrochlorination System
- Laboratory Activated Carbon Adsorption Tank Activated Carbon Adsorption BoxActivated Carbon Adsorption Unit
- Single Reverse Osmosis Equipment for Pure Water
- Codeline Reverse Osmosis Model 80CN30 Membrane Housing End Cap Complete End Plate Assembly Seal Ring Accessory
- Codeline Reverse Osmosis Model 80A30 Membrane Housing End Cap Complete End Plate Assembly Seal Ring Accessory
- Balance Brand Reverse Osmosis ModelBH8S-300 Membrane Housing End Cap Adapter Pressure Plate Plug
- High Torque Waste Metal Shredder Waste Metal Breaker Crusher
- Professional Hard Drive Shredder-mini Small Shredder
- Wholesale Hotsale Pure Water Treatment Custom Size Coal Based Coconut Shell Granular Activated Carbon Made in China
- Wholesale Hotsale Pure Water Treatment Custom Size Coal Based Coconut Shell Granular Activated Carbon Made in China
- Hot Sale Manufacturer Wood Based Black Activated Carbon Coal Based Coconut Shell Activated Carbon In Water Treatment For Water Made in China
Find Similar Products By Category
- Industrial Equipment & Components > Environment Protection Device > Waste Treatment Equipment
- Please Enter your Email Address
- Please enter the content for your inquiry.
We will find the most reliable suppliers for you according to your description.
Send Now-
Linda Han
Hi there! Welcome to my shop. Let me know if you have any questions.
Your message has exceeded the limit.
- Contact supplier for lowest price
- Customized Request
- Request Sample
- Request Free Catalogs
Your message has exceeded the limit.
-
Purchase Quantity
-
*Sourcing Details
Your inquiry content must be between 10 to 5000 characters.
-
*Email
Please enter Your valid email address.
-
Mobile





Rich Pond Water Product Added Bacillus Subtilis

Biological Fertilizer for Phosphate Dissolving
Using Plant Remains to Produce Organic Fertilizer
Composting Convert Organic Wastes to Fertilizer
Composting Agent for Protein-based Materials
SUKAST Bacteria for Septic Tank